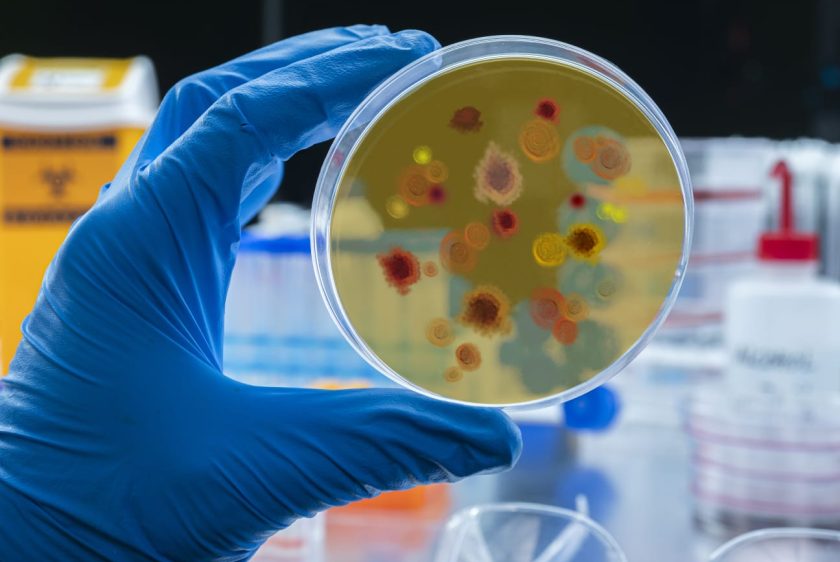

Bogotá se une a la Semana Mundial de Concientización sobre la Resistencia a los Antimicrobianos
- Con prestadores de servicios de salud y la comunidad, en la capital se promueve el uso responsable de los antibióticos, fortalecer la cultura del cuidado de la salud y del medio ambiente.
Bogotá D. C., noviembre 14 de 2025. Bajo el lema ‘Actuemos ya: protejamos nuestro presente, aseguremos nuestro futuro’, la Secretaría Distrital de Salud (SDS) liderará en Bogotá la Semana Mundial de Concientización sobre la Resistencia a los Antimicrobianos (RAM), del 18 al 24 de noviembre.
Para esta iniciativa global, impulsada por la Organización Mundial de la Salud (OMS), la Organización de las Naciones Unidas para la Alimentación y la Agricultura (FAO), el Programa de las Naciones Unidas para el Medio Ambiente (PNUMA) y la Organización Mundial de Sanidad Animal (OMSA), Bogotá realizará encuentros con la comunidad y académicos para intercambiar conocimientos, experiencias y asumir una responsabilidad colectiva frente a los desafíos que plantea el uso indebido de los antimicrobianos para fortalecer la articulación entre los sectores humano, animal y ambiental, bajo el enfoque de ‘Una sola salud’.
La resistencia a los antimicrobianos —explica la OMS— ocurre cuando bacterias, hongos, virus y parásitos dejan de responder a los medicamentos (antimicrobianos), haciendo que los tratamientos sean menos efectivos y aumentando el riesgo de infecciones graves. Solo en 2023, una de cada seis infecciones bacterianas confirmadas fue resistente a los tratamientos con antibióticos y, entre 2018 y 2023, se registró un aumento superior al 40 % en los casos de resistencia.
La Secretaría Distrital de Salud implementa el Modelo MAS Bienestar, que incluye estrategias para la contención de la resistencia antimicrobiana. Estas acciones fortalecen los programas de uso optimizado de antimicrobianos y control de infecciones en hospitales públicos y privados, junto con procesos de formación para profesionales de la salud, pacientes y familiares. Además, la entidad lidera una alianza estratégica con Asocoldro, que busca promover buenas prácticas en farmacias y droguerías, mediante capacitaciones y la creación de la Red de Puntos de Escucha MAS Bienestar.
Estudios de la Universidad Nacional y la Pontificia Universidad Javeriana, en colaboración con la Secretaría Distrital de Salud, revelan que el 43,2 % de los antibióticos en Bogotá se venden sin fórmula médica y que en muchos casos su uso es recomendado por familiares o vendedores sin formación profesional, una práctica que aumenta los riesgos para la salud pública.
“La resistencia a los antimicrobianos es una amenaza silenciosa que avanza más rápido de lo que imaginamos. Desde Bogotá, impulsamos una respuesta integral que combina educación, vigilancia, control y participación comunitaria. Cuidar los antibióticos es cuidar la vida y solo con responsabilidad colectiva lograremos proteger nuestro presente y asegurar el futuro. No se autoprescriba, confíe en el personal de salud y proteja el futuro de todos”, afirmó Julián Fernández, subsecretario de Salud Pública.
Recomendaciones para usar los antibióticos de forma responsable
- No compre antibióticos sin fórmula médica.
- Tómelos sólo si un médico u odontólogo los prescribe.
- No los use para tratar gripa o resfriado: los antibióticos no eliminan virus.
- No insista a su médico para que los formule si no son necesarios.
- No guarde, comparta, ni recomiende antibióticos sobrantes.
- No automedique a sus mascotas sin la orientación de un veterinario.
Cumpla correctamente el tratamiento
- Respete las dosis, horarios y duración indicadas por su médico.
- No aumente ni suspenda el medicamento por su cuenta, aunque se sienta mejor.
- Si los síntomas no mejoran, consulte nuevamente a su profesional de salud.
Cuidemos nuestra salud y el medio ambiente
- Lávese las manos frecuentemente para prevenir infecciones.
- No deseche medicamentos por el inodoro ni en la basura.
- Lleve los medicamentos vencidos o no utilizados a los ‘Puntos Azules’ ubicados en droguerías y centros veterinarios.
También te puede interesar: Conéctate con el programa radial “Es Vital”: la salud en sintonía con tu vida
También te puede interesar: Proteger a nuestras niñas y niños del cáncer está en nuestras manos: vacúnalos contra el VPH